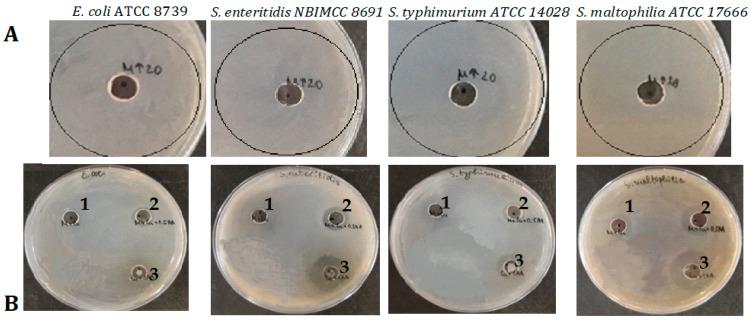
https://cdn.ncbi.nlm.nih.gov/pmc/blobs/71ef/11768038/875d6a6daf68/molecules-30-00291-g010a.jpg

基于蜗牛黏液与抗坏血酸协同作用的抗菌氧化铜纳米颗粒的绿色合成
Green Synthesis of Antibacterial CuO Nanoparticles Based on the Synergy Between Snail Mucus and Ascorbic Acid.
作者信息
Todorova Maria, Kosateva Angelina, Petrova Ventsislava, Ranguelov Bogdan, Atanasova-Vladimirova Stela, Avdeev Georgi, Stoycheva Ivanka, Pisareva Emiliya, Tomova Anna, Velkova Lyudmila, Dolashki Aleksandar, Dolashka Pavlina
机构信息
Institute of Organic Chemistry with Center for Phytochemistry, Bulgarian Academy of Sciences, 1113 Sofia, Bulgaria.
Center of Competence "Clean Technologies for Sustainable Environment-Water, Waste, Energy for Circular Economy", 1000 Sofia, Bulgaria.
出版信息
Molecules. 2025 Jan 13;30(2):291. doi: 10.3390/molecules30020291.
Many biologically active compounds have been identified in the mucus of the garden snail , which are effective in the treatment of several diseases such as cancer, ulcers, wounds, etc. The incorporation of these compounds into the green synthesis of copper nanoparticles (CuONPs-Muc) was demonstrated in our previous study. Based on the synergistic effect of two reducing agents- snail mucus and ascorbic acid (AsA)-on CuSO.5HO, which also act as stabilizers of the resulting compound, a new method for the "green" synthesis of CuONPs-Muc is presented. Using two reducing agents has several advantages, such as forming spherical nanoparticles with a diameter of about 150 nm and reducing the formation time of CuONPs-Muc to 3 h. Analyses by ultraviolet-visible spectroscopy (UV-Vis) and Fourier transform infrared spectroscopy (FT-IR) show the formation of CuONPs-Muc, composed of a mixture of copper and copper oxide. This was confirmed by scanning electron microscopy combined with energy-dispersive spectroscopy (SEM/EDS) and X-ray diffraction (XRD). Another important advantage of CuONPs obtained by the new method with two reducing agents is the stronger inhibitory effect on the bacterial growth of some Gram-positive and Gram-negative bacterial strains, compared to CuONPs-Muc prepared with only one reducing agent, i.e., a fraction of mucus with an MW > 20 kDa.
在花园蜗牛的黏液中已鉴定出许多生物活性化合物,它们对治疗多种疾病有效,如癌症、溃疡、伤口等。在我们之前的研究中已证明将这些化合物用于铜纳米颗粒(CuONPs-Muc)的绿色合成。基于两种还原剂——蜗牛黏液和抗坏血酸(AsA)——对CuSO₄·5H₂O的协同作用,它们同时也是所得化合物的稳定剂,本文提出了一种“绿色”合成CuONPs-Muc的新方法。使用两种还原剂有几个优点,比如形成直径约为150 nm的球形纳米颗粒,并将CuONPs-Muc的形成时间缩短至3小时。通过紫外可见光谱(UV-Vis)和傅里叶变换红外光谱(FT-IR)分析表明形成了由铜和氧化铜混合物组成的CuONPs-Muc。这通过扫描电子显微镜结合能谱分析(SEM/EDS)和X射线衍射(XRD)得到了证实。与仅用一种还原剂(即分子量>20 kDa的部分黏液)制备的CuONPs-Muc相比,用两种还原剂的新方法获得的CuONPs的另一个重要优点是对一些革兰氏阳性和革兰氏阴性细菌菌株的细菌生长具有更强的抑制作用。